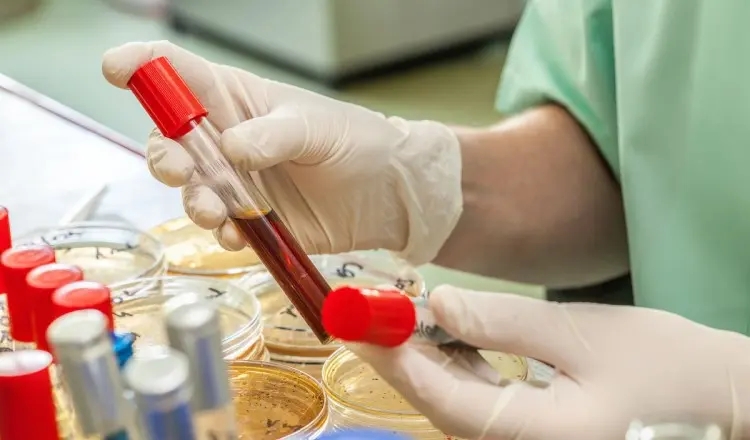

Точно ли нам выполняют анализы? Как контролируют качество исследований в лабораториях
Почему бывают разные результаты?
Раздел: Анализы, исследования (Точность медицинских анализов)
Отвечать в конференциях и заводить новые темы может любой участник, независимо от наличия регистрации на сайте 7я.ру.